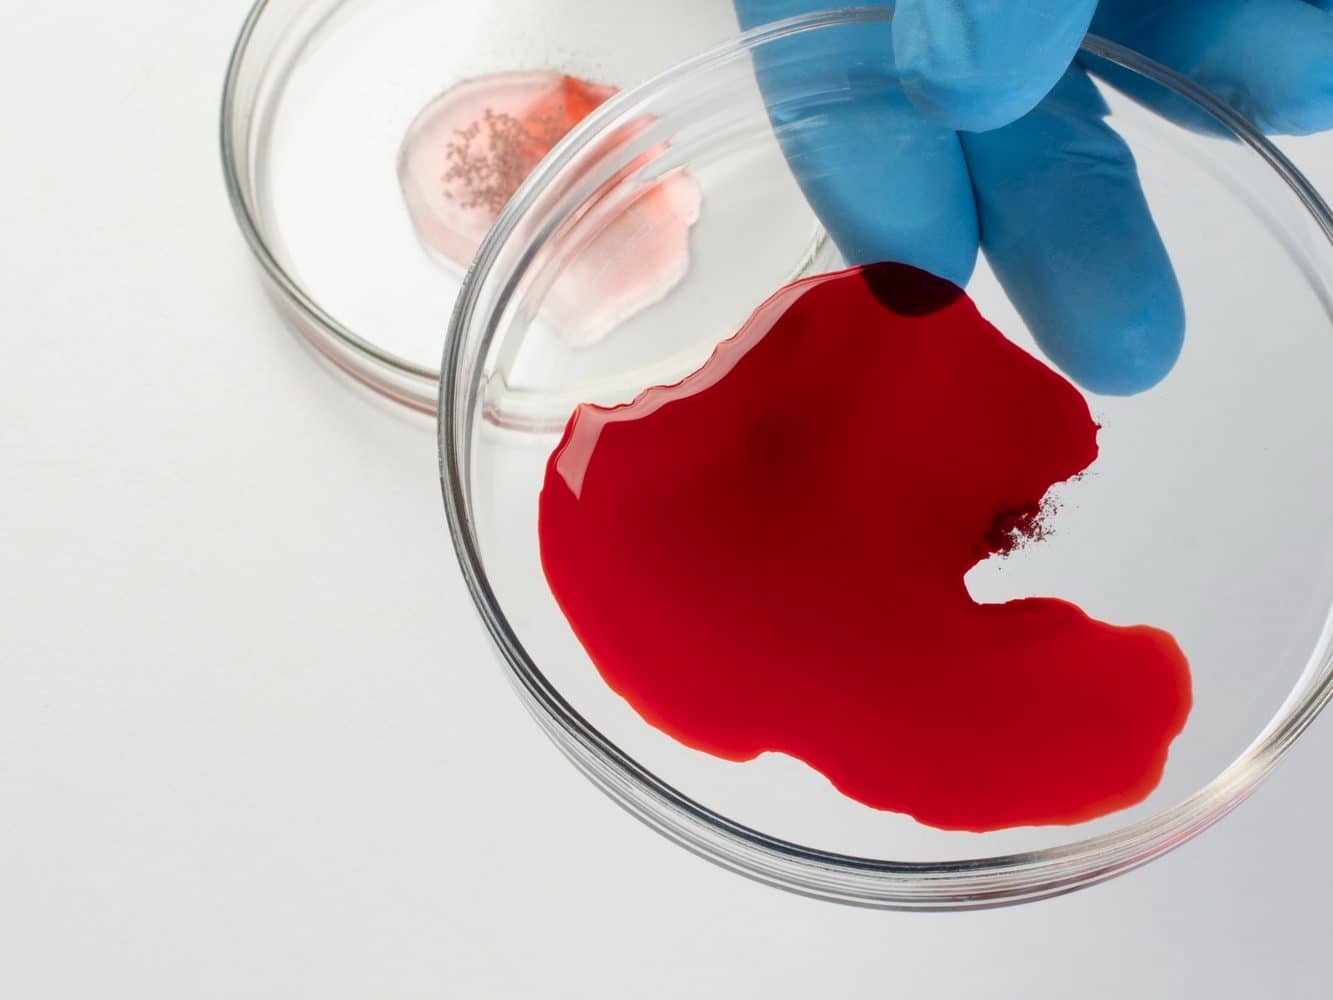

Sangre en las heces: 11 causas principales y las que realmente deberían preocuparte
Ver sangre en las heces asusta, y es normal que la mente se vaya a lo peor. Aun así, muchas veces se debe a causas tratables, sobre todo cuando aparece como sangre roja tras evacuar. La clave está en observar el color (rojo brillante, rojo oscuro o sangre negra) y en fijarse en síntomas que acompañan, como dolor, diarrea o señales de anemia. Nada de esto sirve para “auto-diagnosticarse”, pero sí para saber cuándo conviene actuar rápido.
🚨 Noticias al instante en WhatsApp
Únete GRATIS al canal de Aurana y recibe las alertas más importantes antes que todos.
👉 Seguir canal en WhatsApp¿Cómo reconocer el tipo de sangrado según el color y la forma en que aparece?
La sangre roja brillante suele verse en el papel higiénico o en la superficie de las heces, y con frecuencia se origina cerca del ano. Cuando la sangre aparece mezclada con las heces, o es rojo oscuro, el origen puede estar más arriba en el colon. Las heces negras, pegajosas o con aspecto de alquitrán (melena) sugieren sangrado digestivo más alto y requieren valoración. Si el patrón se repite, aunque sea poco, lo prudente es consultarlo.
Sangre roja brillante al limpiarse, lo más habitual y lo que suele causarlo
Cuando la sangre aparece al limpiarse, lo más típico es que haya hemorroides o una fisura anal, a menudo tras esfuerzo por estreñimiento. Suelen acompañarse de picor, sensación de bulto o escozor. En la fisura es común el dolor al evacuar y el miedo a ir al baño, lo que empeora el estreñimiento y mantiene el problema.
Sangre oscura, sangre mezclada o heces negras, cuándo pensar en algo más serio
La sangre más oscura o mezclada con las heces puede apuntar a inflamación, lesiones o sangrado en el colon. Si además hay cansancio, palidez o falta de aire, puede haber sangrado oculto con caída de hierro. Las heces negras no se deberían pasar por alto, sobre todo si aparecen con malestar general o mareo.

Once causas principales de sangre en las heces, desde las más comunes hasta las que requieren estudio
Las hemorroides suelen dar sangre roja brillante y molestia anal; la fisura anal causa un corte doloroso con sangrado al final de la evacuación; el estreñimiento con heces duras favorece heridas y sangrado por rozamiento; los divertículos pueden provocar sangrado rojo oscuro a veces abundante y sin dolor; los pólipos pueden sangrar de forma intermitente y sin síntomas; la colitis infecciosa suele dar diarrea con sangre, dolor tipo retortijón y, a veces, fiebre; la enfermedad inflamatoria intestinal (Crohn o colitis ulcerosa) tiende a causar brotes con diarrea, urgencia y sangre mezclada; la proctitis suele dar tenesmo (ganas de evacuar sin hacerlo) y moco con sangre; la angiodisplasia puede causar sangrados repetidos, a veces indoloros, sobre todo en personas mayores; la colitis isquémica aparece con dolor abdominal y sangre tras un inicio brusco; el cáncer colorrectal puede manifestarse con sangrado persistente, cambios del ritmo intestinal o anemia sin una causa clara.
Señales de alarma, las situaciones que sí deberían preocupar y pedir ayuda rápida
Conviene buscar ayuda sin demora si hay sangrado abundante o con coágulos, mareo o desmayo, dolor abdominal fuerte, fiebre alta con diarrea sanguinolenta, pérdida de peso sin explicación, un cambio nuevo y persistente del hábito intestinal, antecedentes familiares de cáncer de colon, o signos de anemia como cansancio marcado y palidez. No confirman un diagnóstico, pero sí justifican una valoración urgente o pronta.
¿Cuándo ir a urgencias y cuándo pedir cita prioritaria?
Se recomienda urgencias si hay debilidad intensa, desmayo, sangrado que no para o empeora, o heces negras con mal estado general. Una cita prioritaria encaja cuando el sangrado se repite, cuando la sangre es oscura o va mezclada, o si existen factores de riesgo (edad, antecedentes, anemia).
¿Qué suele hacer el médico y qué se puede hacer en casa mientras se espera?
El médico suele preguntar por cantidad, color y frecuencia, explorar la zona anal si procede, y pedir analítica para descartar anemia. Según el caso, puede solicitar pruebas de heces y valorar rectoscopia o colonoscopia. Mientras se espera, suele ser seguro reforzar la hidratación, aumentar la fibra si hay estreñimiento, evitar el esfuerzo al evacuar y no automedicarse con antiinflamatorios si hay sangrado. Si se usan anticoagulantes, conviene revisarlos con el profesional que los indicó.
La sangre en las heces puede venir de algo frecuente y local, o de causas que necesitan estudio, y el patrón del sangrado junto con los síntomas orienta los pasos. Si se repite, si cambia el color, o si aparecen señales de alarma, lo más sensato es pedir consulta médica cuanto antes.
Este artículo ha sido elaborado con el apoyo de una herramienta de inteligencia artificial. Posteriormente, ha sido objeto de una revisión exhaustiva por parte de un periodista profesional y un redactor jefe, garantizando así su exactitud, relevancia y conformidad con los estándares editoriales. Aurana se esfuerza por transmitir el conocimiento sobre salud en un lenguaje accesible para todos. EN NINGÚN CASO la información proporcionada puede sustituir la opinión de un profesional sanitario.




